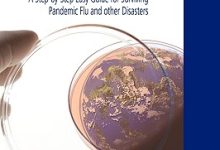

2023年“两癌”筛查公告
为扎实开展2023年省委、省政府关爱妇女、预防和早期发现危害妇女健康的两大癌症(宫颈癌、乳腺癌),切实关爱妇女。有关事项通知如下:

一、检查乡镇范围:
尼玛镇、欧拉镇、采日玛镇、欧拉秀玛镇、尼玛社区、卓格社区

二、检查对象:
33-64岁的牧村妇女(2020-2022年)三年内未参加“两癌”检查。
2.三年内(2020-2022年)未参加“两癌”检查的城市低收入家庭主妇(城市低收入家庭主妇、特困供养、下岗、失业、公益岗位、零工等)。).

三、检查注意事项:
1.检查时请携带身份证或户口簿。
2.检查前三天避免同房。
3.检查时避免生理月经期。
四、检查时间和地点
1.县妇幼保健院:周一-周五,上午9:00-12:00下午2:30-6:00
2.乡镇(场)组织符合条件的适龄妇女集中在所属卫生院检查,时间以县妇联通知为准。
五、咨询热线
0941-6121278
六、附:
宫颈癌、HPV、TCT有什么关系?知识点?
玛曲县妇联
玛曲县妇幼保健院
2023年2月21日
宫颈癌、HPV、TCT有什么关系?
宫颈癌是什么?
宫颈癌是女性生殖系统中最常见的恶性肿瘤,发病率为50~55岁,但近年来,宫颈癌的发病率在年轻女性中逐年上升。
宫颈癌的症状是什么?
当宫颈细胞首次出现异常时,通常没有预警症状。随着肿瘤的发育,可能会出现以下症状:
1、阴道分泌物异常
2、阴道出血在非生理周期时出血
3、绝经后出血
4、性交时出血或疼痛
宫颈癌和HPV有什么关系?
HPV病毒,中文称为乳头状瘤病毒,是某一类型病毒的总称。HPV中有40种可感染生殖器部位,其中一些是导致宫颈癌的高危因素。
根据风险,可能导致宫颈病变和宫颈癌的HPV亚型被称为高风险,最常见的是HPV16和18,而低风险的HPV被称为低风险。
在大多数情况下,生殖器感染HPV病毒后可以自愈,没有危险,不必对高危HPV阳性而紧张。
如果一些HPV被感染并转化为慢性HPV,可能会导致宫颈细胞病变,这可能会导致癌症。毫不夸张地说,90%的宫颈癌是由HPV病毒引起的,因此被称为罪魁祸首。
HPV如何引起宫颈癌?
如果高危亚型HPV病毒株潜伏在人体内,可能会导致宫颈细胞异常。这些癌前病变并不一定意味着癌症,但随着时间的推移,异常细胞可能会为成为癌细胞创造条件。肿瘤一旦出现,就会在宫颈及周围扩散。
什么是TCT?
TCT检测是液基薄层细胞检测的缩写,采用液基薄层细胞检测系统检测宫颈细胞和细胞学分类诊断,是世界上最先进的宫颈癌细胞学检测技术,与传统的宫颈刮片巴氏杀菌涂片检测显著提高了标本满意度和宫颈异常细胞检测率。TCT报告的结果主要分为以下7种:
1、上皮内病变细胞或恶性细胞未见(NILM):说明宫颈细胞正常,不需要特殊治疗。
2、非典型鳞状细胞不能明确其含义(ASC-US):这意味着宫颈细胞可能有病变。如果结合高危HPV感染,需要阴道镜下的宫颈活检。如果没有高危HPV感染,TCT可以在3月至6月后复查。
3、非典型鳞状细胞不排除高度鳞状上皮病变(ASC-H):说明宫颈细胞有癌前病变或癌症,但细胞异常诊断不准确,需要阴道镜下宫颈活检诊断。
4、鳞状上皮内病变低(LSIL):说明宫颈细胞可能有低级癌前病变,需要阴道镜下宫颈活检进一步诊断。
5、高度鳞状上皮内病变(HSIL):说明宫颈细胞有可疑的高级癌前病变,需要阴道镜下宫颈活检诊断。
6、非典型腺细胞(AGC):说明宫颈管细胞有一些病变,需要阴道镜检查和宫颈管组织检查诊断。
7、鳞状细胞癌:说明宫颈细胞已经癌变。如果组织类型明确,报告为角化鳞状癌、非角化鳞状癌等。
HPV和TCT有什么关系?
简单总结一下这两种检查之间的关系。HPV检测高危病毒感染是否可能导致宫颈病变和宫颈癌。TCT检查宫颈细胞在致病因素的作用下是否发生异常变化,即HPV检查原因,TCT检查结果。因此,只有结合这两个结果,医生才能做出准确的诊断。
由于高危HPV持续感染是宫颈癌的必要条件,为了尽快发现宫颈癌前病变和宫颈癌,建议只要3年以上女性和30岁以上女性,最好每年进行高危HPV和TCT检查,如果连续两年检查结果正常,可间隔2-3年检查一次。HPV和TCT检查都收集了宫颈表面的脱落细胞,所以患者在保留标本时没有疼痛感,所以没有必要对检查过于紧张和焦虑。
宫颈癌是所有癌症中唯一明确的原因(高危HPV)、唯一能早期预防和治疗的癌症,唯一能彻底根除的癌症。因此,女性朋友可以远离最常见的妇科恶性肿瘤,只要定期进行科学合理的筛查和随访。
玛曲县妇幼保健院